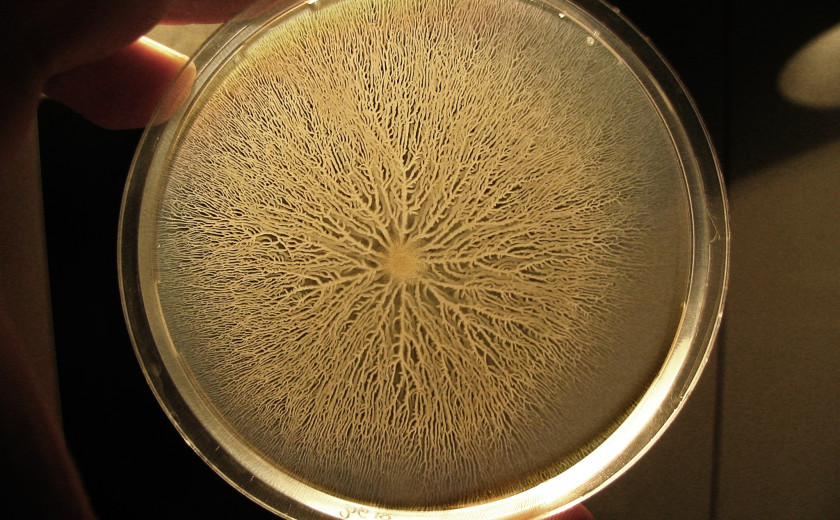

Fiziološka cena odpornosti proti antibiotikom
Z razširjeno uporabo antibiotikov v zdravstvu in živinoreji vse večji problem postaja tudi odpornost bakterij proti antibiotikom. Ameriško raziskovalno skupino je zanimalo, če razvoj odpornosti predstavlja tudi svojevrstno breme za bakterije. Izsledke raziskave so objavili v reviji Science Advances.
Ena izmed pogostih tarč za antibiotike so bakterijski ribosomi - celični kompleksi, zaslužni za sintezo proteinov. Primer takšnega antibiotika je eritromicin, ki z vezavo na veliko podenoto ribosoma onemogoča izhod nastajajoče polipeptidne verige in tako zavira nastanek proteinov, brez katerih bakterijska celica ne preživi. Določen sev bakterije Bacillus subtilis se pred delovanjem antibiotika zaščiti s spremenjenim ribosomom, ki zaradi mutacije ribosomskega proteina L22 onemogoča vezavo eritromicina in tako zavira njegovo delovanje. Pričakovali bi torej, da bodo zaradi razvite odpornosti spremenjeni ribosomi sčasoma nadomestili ribosome divjega tipa, vendar se to v naravi ni zgodilo. Raziskovalno skupino je zato zanimalo, ali pridobljena odpornost za bakterijo predstavlja fiziološko breme.
V raziskavi so vzpostavili kokulturo dveh sevov Bacillus subtilis – divjega tipa in seva s spremenjeno različico ribosoma. Nato pa so ju 12 ur gojili ob prisotnosti in odsotnosti neletalne koncentracije eritromicina in različnih koncentracijah magnezijevih ionov. Tako so želeli preučiti morebiten vpliv dostopnosti magnezijevih ionov, ki sodelujejo pri vzdrževanju stabilnosti ribosomskih podenot, na uspešnost rasti odpornega in neodpornega seva. Oba seva sta bila v odsotnosti antibiotika primerljivo uspešna pri vseh koncentracijah magnezijevih ionov. Ob prisotnosti antibiotika pa se je pri višanju koncentracije magnezijevih ionov v uspešnosti sevov pojavila razlika. Pri koncentraciji magnezijevih ionov 0,02 milimola na liter je bil uspešnejši sev divjega tipa, pri stokrat večji koncentraciji pa sev s spremenjenimi ribosomi. To nakazuje kompromis v prilagajanju na koncentracijo magnezijevih ionov in prisotnost antibiotika. V primeru nizke koncentracije magnezijevih ionov je namreč kljub prisotnosti antibiotika uspešnejši sev, ki nanj ni odporen.
V nadaljevanju so zato analizirali koncentracijo prostega magnezija v bakterijskih celicah obeh sevov. Ugotovili so, da sev s spremenjenimi ribosomi ni sposoben ohranjati primerne koncentracije znotrajceličnega magnezija, saj ga s pretirano vezavo kopiči tudi, ko je ta prisoten v omejenih količinah. Posledično je manj znotrajceličnega magnezija na voljo za druge funkcije.
Poleg ribosomov znotraj bakterijske celice največji delež magnezijevih ionov vežejo molekule adenozin-trifosfata oziroma ATP. ATP predstavlja glavni vir energije v celici in je aktiven le, ko je nanjo vezan magnezijev ion. Raziskovalna skupina je zato primerjala koncentracijo aktivnega ATP v obeh analiziranih sevih. Ugotovili so, da se koncentracija aktivnega ATP zmanjša pri koncentraciji, kjer sev divjega tipa postane dominanten v kokulturi, kar nakazuje fiziološko breme pretiranega kopičenja magnezija v celici s strani spremenjenih ribosomov. Sev divjega tipa pa je zmožen ohranjati primerno koncentracijo prostih magnezijevih ionov in aktivnega ATP tudi pri nižjih koncentracijah magnezija.
Študija pojasnjuje, da je lahko razvoj odpornosti za bakterijsko celico prednost ali breme, odvisno od pogojev v okolju. V določenih pogojih, denimo ob pomanjkanju magnezijevih ionov, so lahko uspešnejši neodporni sevi, kar je vzrok, da se ti v naravi ohranjajo. Gre torej za kompromis med razvojem odpornosti in fiziološkim bremenom, ki ga ta prinaša. Razumevanje tega kompromisa pa je ključno za razvoj alternativnih načinov spopadanja z odpornimi sevi.
Manj odpornih sevov si želi Gaja.

Dodaj komentar
Komentiraj